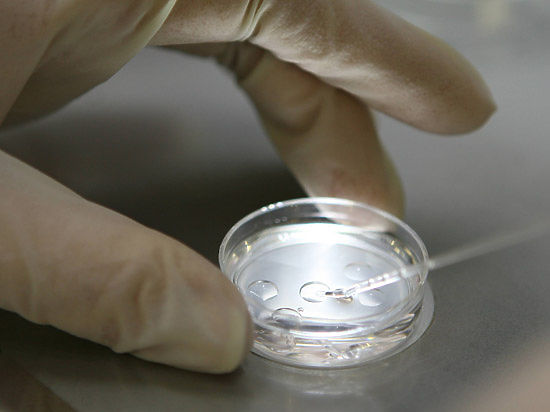

|
Мракобиология
|
|
| Cost | Дата: Понедельник, 27.10.2014, 16:45 | Сообщение # 166 |
 Генералиссимус
Группа: Модераторы
Сообщений: 3651
Репутация: 9
Статус: Offline
| Глобус Эбола
_http://www.kommersant.ru/doc/2585029_

Полгода безуспешной борьбы с эпидемией лихорадки Эбола рождают мрачные сценарии. Счет жертв может пойти на сотни тысяч. Развитые страны давно могли создать вакцину против Эбола-вирусов, но не создали. Вложения в препарат для жителей беднейшего региона мира казались неоправданными. Теперь эту позицию приходится пересматривать.
Месяц назад Всемирный банк опубликовал несколько документов, посвященных анализу экономических последствий эпидемии. В 2014 году вспышка лихорадки обойдется Гвинее в $130 млн (2,1% ВВП), Либерии — в $66 млн (3,4% ВВП), Сьерра-Леоне — в $163 млн (3,3% ВВП). В общей сложности эти государства недосчитаются $359 млн.
Оценивая долгосрочный эффект, эксперты организации исходят из двух сценариев — позитивного (Low Ebola) и негативного (High Ebola). Если к концу года развитие эпидемии существенно замедлится, экономика Гвинеи ощутимых потерь уже не понесет, а Сьерра-Леоне и Либерия недосчитаются соответственно 1,2% и 4,2% ВВП, всего — $97 млн. Если же темпы снизятся несильно (то, что они будут нарастать, эксперты даже не рассматривают) и при этом эпидемия распространится за пределы трех государств, потери Гвинеи, Сьерра-Леоне и Либерии составят соответственно 2,3%, 8,7% и 11,7% — в общей сложности это более $800 млн.
При любом развитии событий эпидемия Эбола окажет влияние на экономику всей Западной Африки. По итогам 2014 года потери составят не менее $2,2 млрд, а в худшем случае — $7,4 млрд. К концу следующего года при реализации сценария High Ebola ущерб может превысить $32 млрд. Впрочем, то, что в соседних странах, в первую очередь в Нигерии, пока все хорошо, заставляет экспертов склоняться к тому, что катастрофический сценарий реализован не будет.
|
| |
| |
| Cost | Дата: Понедельник, 27.10.2014, 16:48 | Сообщение # 167 |
 Генералиссимус
Группа: Модераторы
Сообщений: 3651
Репутация: 9
Статус: Offline
| Ученые предсказали зимний взрыв Эболы
_http://www.dni.ru/tech/2014/10/27/284602.html_

Американские ученые из Йельского университета воспользовались математической моделью расчета распространения вируса Эбола. Оказалось, что смертельно опасная болезнь "взорвется" в середине декабря и убьет тысячи людей по всему миру.
При этом распространение болезни грозит не только Африке, но и Европе, Северной и Южной Америке, а также Азии. Ученые в своем отчете предупреждают, что возможность взять эпидемию под контроль, которой в настоящее время располагают власти, стремительно сокращается. По их мнению, уже через несколько недель нельзя будет что-либо сделать.
По расчетам ученых, количество случаев заражения вирусом Эбола увеличится в пять раз. Без срочной дополнительной помощи к 15 декабря жертвами лихорадки станет 171 тысяча человек, что составляет 12% жителей самого густонаселенного округа Либерии – Монтсеррадо. Как выяснили американские ученые, инфицированный либериец способен передать инфекцию одновременно двум-трем людям.
По данным ВОЗ на 25 октября 2014 года, число инфицированных вирусом Эбола превысило десять тысяч человек, из них скончались 4922. Подавляющее число случаев приходится на Либерию, Гвинею и Сьерра-Леоне. В Либерии ситуация наиболее тяжелая: там отмечено 2705 летальных исходов.
|
| |
| |
| Cost | Дата: Среда, 29.10.2014, 20:13 | Сообщение # 168 |
 Генералиссимус
Группа: Модераторы
Сообщений: 3651
Репутация: 9
Статус: Offline
| Эболажа: подтверждается искусственное происхождение эпидемии Эбола
_http://www.ridus.ru/news/170564_
Несколько дней назад, житель Ганы по имени Нана Кваме сделал заявление, которое потрясло интернет-сообщество. Приведенная ниже информация должна быть распространена. Нам нужно понять, что такое Эбола. Мир должен увидеть настоящие цели стоящие за истерией, раздуваемой вокруг Эболы. Вот как Нана Кваме описал происходящее в его родной стране:
«Люди Западного мира должны знать, что происходит здесь, в Западной Африке. Все, что вам говорят - ложь!!! «Эбола» как вирус НЕ существует и НЕ распространяется. «Красный крест» привез это заболевание в четыре конкретные страны по четырем конкретным причинам, и жертвами этой болезни становятся только те, кто получал медицинскую помощь или инъекции в «Красном кресте». Вот почему либерийцы и нигерийцы начали выгонять «Красный крест» из своих стран и распространять правдивую информацию в новостях.
Из страха, что «лекарство» для исцеления не будет доступно для них, черное население будет стремиться пройти вакцинацию. Они будут осаждать клиники толпами и будут очень серьезные проблемы. Учитывая всю информацию о вакцинациях, которая доступна сегодня, хотелось бы надеяться на благоразумие людей. Впрочем все, что остается делать это как раз надеяться. Так как Запад рассчитывает именно на нашу необразованность при реализации своих планов.
Спросите себя: если Эбола так опасна и может легко передаваться от человека к человеку, а не через контролируемую вакцинацию, то почему центры по контролю и профилактике заболеваний, и правительство США не перекрыли воздушное сообщение со странами, в которых бушует «эпидемия»? Почему хотя бы не вводят жесткий контроль? Мы должны начать думать и распространять информацию в мировом масштабе, так как мировые СМИ не передают правдивой и объективной информации о людях, живущих здесь, в Западной Африке. Они врут, исходя из своих целей, а у нас не хватает людей, имеющих возможность раскрывать истинное положение дел. Сотни тысяч людей погибли, были парализованы или стали инвалидами в результате применения этой, и многих других «новых» вакцин по всему миру, и мы наконец-то начинаем видеть, что происходит на самом деле. Так что же нам делать с этой информацией?
Необходимо отметить, что начало эпидемии Эболы совпало с масштабными проведениями вакцинаций в затронутых вирусом странах. Программы вакцинаций проходили под эгидой ООН. Фармацевтические и биотехнические компании могут извлечь огромную прибыль из кризиса, связанного с вирусом Эбола. Высшие военные чины, правительственные структуры, а также бюрократы из ООН готовы платить миллионы евро за их услуги в области научных исследований и разработок. Довольно странным совпадением является тот факт, что самые ранние случаи заболевания Эболой в Гвинее совпали с тремя масштабными кампаниями по вакцинации, проводимыми в этой стране Всемирной организацией здравохранения (ВОЗ) и детским фондом ООН ЮНИСЭФ. Две из этих программ вакцинаций были проведены организацией «Врачи без границ» (Medicins Sans Frontieres), а сами вакцины были произведены французской фармацевтической корпорацией «Sanofi Pasteur», крупнейшим акционером которой является «Rothschild Group». Ротшильды управляют почти всеми центральными банками в мире и их финансовая империя оценивается примерно в 500 триллионов долларов. Они управляют всем на этой планете и, несомненно, они извлекут выгоду из этой эпидемии.
Вы все еще думаете, что это очередная «теория заговора»? Посмотрите вот это:

На видео видно, как человек без спецкостюма и без маски спокойно подходит к носилкам, на которых лежит больной Эболой человек.
Похоже, что они забыли про камеры наблюдения.
|
| |
| |
| Cost | Дата: Воскресенье, 02.11.2014, 22:16 | Сообщение # 169 |
 Генералиссимус
Группа: Модераторы
Сообщений: 3651
Репутация: 9
Статус: Offline
| Американские ученые предложили лечить Эболу марихуаной
_http://riafan.ru/132389-amerikanskie-uchenyie-predlozhili-lechit-ebolu-marihuanoy/_

По мнению специалистов, марихуана будет оказывать психологически расслабляющее действие на пациентов, а также поможет организму в сопротивлении заболеванию на молекулярном уровне, укрепив иммунитет заболевшего.
По данным немецкого издания Bild, многие ученые уже доказали, что благодаря воздействию на механизмы иммунозащиты психоактивные вещества, в частности, марихуана, способны содействовать противостоянию многим инфекциям, как бактериальным заражениям, так и вирусным заболеваниям.
Скоро поступят сведения от российских ученых о способах профилактики лихорадки Эбола с помощью водки. 
|
| |
| |
| astlab | Дата: Понедельник, 03.11.2014, 09:20 | Сообщение # 170 |
 Admin
Группа: Администраторы
Сообщений: 930
Репутация: 2
Статус: Offline
| Цитата Cost (  ) На видео видно, как человек без спецкостюма и без маски спокойно подходит к носилкам, на которых лежит больной Эболой человек.
Похоже, что они забыли про камеры наблюдения.
Нет не забыли. Эбола не грипп и по воздуху не распространяется. А то уже 5 млрд. заболело бы.
|
| |
| |
| Cost | Дата: Понедельник, 03.11.2014, 17:02 | Сообщение # 171 |
 Генералиссимус
Группа: Модераторы
Сообщений: 3651
Репутация: 9
Статус: Offline
| Есть поговорка: "Лучше перебдеть, чем недобдеть". Бесстрашие обычно демонстрируют в других местах.
У этого человека не было никаких гарантий, что у больного именно в этот момент не начнется рвота, чихание, лопанье кровавых волдырей под кожей или другие явления разбрызгивания мелких капелек жидкости.
Беда обычно приходит с неожиданной стороны.
Не стоит думать, что все 20 000 заразившихся занимались сексом с летучими мышами.
|
| |
| |
| Cost | Дата: Суббота, 29.11.2014, 22:23 | Сообщение # 172 |
 Генералиссимус
Группа: Модераторы
Сообщений: 3651
Репутация: 9
Статус: Offline
| Почти 7 тысяч человек в мире стали жертвами лихорадки Эбола
_http://www.rg.ru/2014/11/28/ebola-anons.html_
Число жертв лихорадки Эбола в мире достигло 6 928 человек, передает "Интерфакс" сообщение Всемирной организации здравоохранения. При этом количество заразившихся достигло 16 169 человек.
|
| |
| |
| Cost | Дата: Понедельник, 15.12.2014, 17:21 | Сообщение # 173 |
 Генералиссимус
Группа: Модераторы
Сообщений: 3651
Репутация: 9
Статус: Offline
| В космосе заработали батарейки из микробов
_http://www.mk.ru/science/2014/12/14/v-kosmose-zarabotali-batareyki-iz-mikrobov.html_
Российские ученые впервые испытали прототип био-электростанции на космическом спутнике
Особым этапом эксперимента стал запуск био-энергостанции в космос на спутнике «Фотон М-4». Как заявил «МК» руководитель направления, завотделом микробиологической безопасности ИМБП РАН Вячеслав Ильин, ни отсутствие гравитации, ни сильные перегрузки, не повлияли на скопище бактерий. В космическом аппарате они дружно вырабатывали до 100 микромпер, чего могло вполне хватить для подзарядки гаджета. Био-батарейки могут использоваться в качестве вечного энергетического источника и в космическом полете, и на земле, в больших энергостанциях, построенных возле станций аэрации.
|
| |
| |
| Cost | Дата: Воскресенье, 21.12.2014, 19:59 | Сообщение # 174 |
 Генералиссимус
Группа: Модераторы
Сообщений: 3651
Репутация: 9
Статус: Offline
| ВОЗ опубликовала новые данные о смертности от лихорадки Эбола
_http://www.1tv.ru/news/health/274338_
Число погибших от лихорадки Эбола впервые превысило 7 тысяч человек, а зараженных - более 19 тысяч. Такие данные обнародовала Всемирная организация здравоохранения. Таким образом, всего за несколько дней списки умерших и заболевших пополнились почти тысячей имен.
Все случаи инфицирования зафиксированы в трёх западно-африканских странах - Либерии, Гвинее и Сьерра-Леоне. Эпидемия продолжается уже год, вакцина против вируса до сих пор не создана. Пока лечение проводится экспериментальными препаратами.
|
| |
| |
| Cost | Дата: Понедельник, 02.03.2015, 08:30 | Сообщение # 175 |
 Генералиссимус
Группа: Модераторы
Сообщений: 3651
Репутация: 9
Статус: Offline
| Вице-президента Сьерра-Леоне изолировали после смерти охранника от Эбола
_http://tengrinews.kz/other/vitse-prezidenta-serra-leone-izolirovali-smerti-ohrannika-270890/_
Вице-президент Сьерра-Леоне Самуэль Сам-Суман помещен на 21-дневный карантин после того, как один из его охранников скончался от вируса Эбола.
За неделю, с 15 по 22 февраля, в регионе было зафиксировано 99 случаев заражения лихорадкой Эбола, 63 из них - в Сьерра-Леоне.
По последним данным Всемирной организации здравоохранения, лихорадкой Эбола в трех западноафриканских государствах заразились почти 24 тысячи человек, 9,6 тысячи скончались. В Либерии от Эболы умерли более 4 тысяч человек.
|
| |
| |
| Cost | Дата: Понедельник, 02.03.2015, 23:41 | Сообщение # 176 |
 Генералиссимус
Группа: Модераторы
Сообщений: 3651
Репутация: 9
Статус: Offline
| Утечка смертельно опасной бактерии произошла в лаборатории в США
_http://ria.ru/world/20150302/1050514822.html_
Утечка опасных бактериологических культур произошла в лаборатории с повышенной системой безопасности в американском штате Луизиана.
После утечки на прилегающих территориях были проведены исследования образцов почвы и воды, в которых бактерию не обнаружили. Однако в ноябре бактерию нашли в организме четырех макак, которые жили в вольерах на большом расстоянии от лаборатории. В январе заразился и следователь, посещавший лабораторию в рамках изучения обстоятельств инцидента.
По официальным данным, угрозы массового заражения людей из-за утечки нет, однако эксперты утверждают, что исследование последствий инцидента проводилось недостаточно тщательно. В частности, по их мнению, специалисты изучали незначительное количество образцов почвы, учитывая, что научный центр расположен в болотистой местности, а через дорогу от здания находится школа.
Бактерия поражает людей и животных, которые контактируют с зараженной почвой либо водой. Возбудитель вызывает мелиоидоз — острую инфекционную болезнь, которая сопровождается тяжелым сепсисом и образованием абсцессов. В том случае, если заболевание протекает в острой форме, больной умирает через 2-4 дня от инфекционно-токсического шока.
Что же они лабораторию с биологической угрозой располагают напротив школы?
Специалисты, блин!
|
| |
| |
| Cost | Дата: Вторник, 03.03.2015, 19:06 | Сообщение # 177 |
 Генералиссимус
Группа: Модераторы
Сообщений: 3651
Репутация: 9
Статус: Offline
| Жизнь на Титане может существовать в метановой атмосфере
_http://rosregistr.ru/nauka/17587.html_

По предположению коллектива научных сотрудников из Корнельского университета, жизнь может присутствовать на Титане в непривычной форме. Метановая атмосфера объекта могла породить формы, основанные на чуждых для органических видов элементах. Местные формы могли успешно приспособиться к метану вместо кислорода.
В процессе работы они сформулировали гипотезу, согласно которой жизнь могла зародится на основе метана. В своей научной лаборатории они создали модель клеточной мембраны, способной функционировать в сложных условиях Титана. Уникальные клетки, которые удалось синтезировать ученым, назвали «azotosome».
Эксперты уверены, дополнительным стимулом для создания подобных мембран на спутнике Сатурна, служат метановые озера на его поверхности.
|
| |
| |
| Cost | Дата: Понедельник, 23.03.2015, 06:53 | Сообщение # 178 |
 Генералиссимус
Группа: Модераторы
Сообщений: 3651
Репутация: 9
Статус: Offline
| Из-за Эболы жителям Сьерра-Леоне запретили покидать свои дома
_http://www.dialog.ua/news/47570_1427010588_

Президент Сьерра-Леоне Эрнест Бай Корома запретил всем жителям страны покидать свои дома в течение трех дней с целью остановить распространение лихорадки Эбола.
Распоряжение президента является частью общенациональной кампании против распространения Эболы, которая займет четыре недели.
Подобный общенациональный режим строгой изоляции уже вводили в стране осенью прошлого года. Тогда он продлился три дня.
|
| |
| |
| Cost | Дата: Вторник, 31.03.2015, 21:01 | Сообщение # 179 |
 Генералиссимус
Группа: Модераторы
Сообщений: 3651
Репутация: 9
Статус: Offline
|
Тем, кто болел Эболой, запретили заниматься сексом
_http://www.amic.ru/news/301982/_
Возможно, что вирус Эбола передается половым путем. В связи с тем, что эта гипотеза пока не опровергнута, людям, перенесшим одноименную лихорадку, Всемирная организация здравоохранения рекомендует воздерживаться от секса и незащищенных контактов на протяжении примерно трех месяцев.
Также отметим, что на днях стало известно о том, что в Гвинее были снова зафиксированы множественные случаи заражения. Некоторые из них были выявлены в больницах и поликлиниках, которые из-за этого пришлось закрыть на карантин. В результате, руководство страны приняло решение о введении режима чрезвычайной ситуации на 45 дней.
|
| |
| |
| Cost | Дата: Понедельник, 20.04.2015, 00:22 | Сообщение # 180 |
 Генералиссимус
Группа: Модераторы
Сообщений: 3651
Репутация: 9
Статус: Offline
| Почти 20 человек погибли в Нигерии от загадочной болезни
_http://www.vesti.ru/doc.html?id=2515009_

Представитель медицинских властей нигерийского штата Ондо Дайо Адйанджу сообщил, что инфицированы 23 человека, зафиксировано 18 смертей. Ранее официальный представитель администрации штата сообщил, что вспышка загадочной заразной болезни впервые была отмечена в начале недели в городе Оде-Иреле, передает ТАСС. Среди симптомов заболевания — острая головная боль, потеря сознания, проблемы со зрением, потеря массы тела. Смерть заболевших наступает в течение суток после появления первых признаков заболевания.
Первые проведенные анализы пока не указывают на то, что болезнь имеет отношение к вирусу Эбола.
Эбола №2?
|
| |
| |